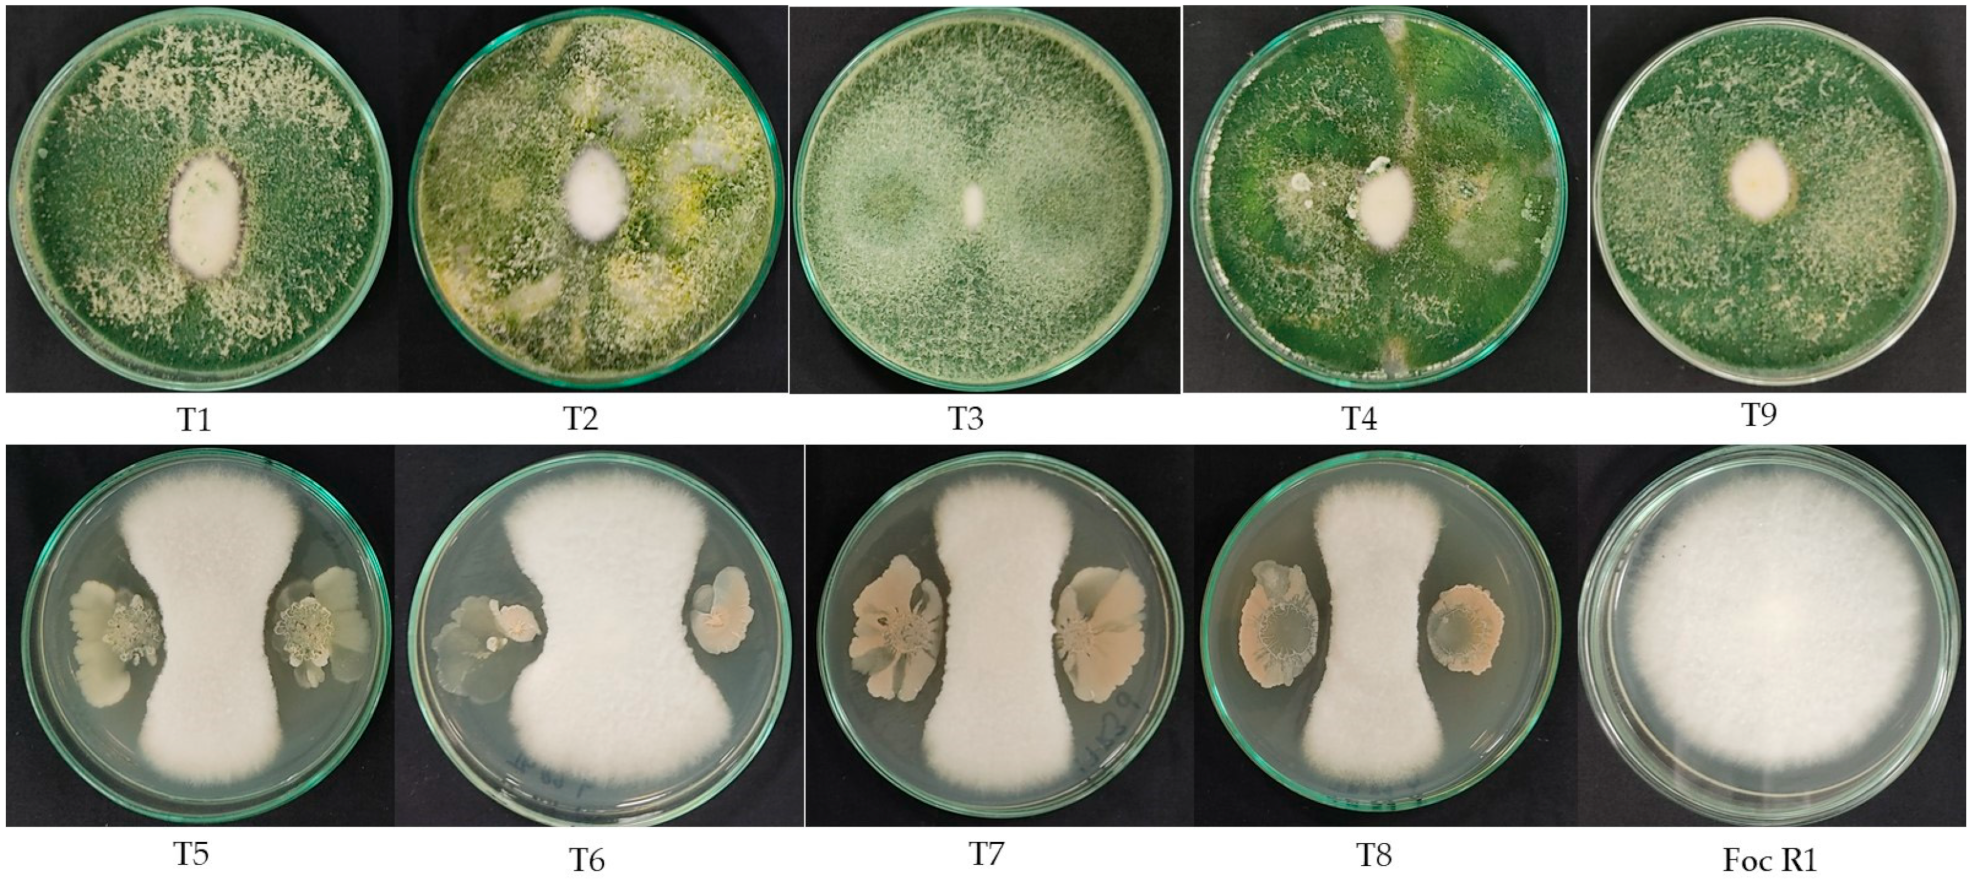
Jof 10 00419 g007

Microbial-Based Biofungicides Mitigate the Damage Caused by Fusarium oxysporum f. sp. cubense Race 1 and Improve the Physiological Performance in Banana
Abstract
1. Introduction
2. Materials and Methods
2.1. Selection of Biofungicides
2.2. Plant Material and Foc R1 Strain
2.3. Production of Foc R1 Inoculum for In Vivo Experiment
2.4. Treatments Application Scheme
2.5. Experimental Design and Measured Disease Variables
2.6. Physiological and Plant Growth Variables
2.7. Molecular Detection of Foc in Plant Tissues
2.8. In Vitro Antagonism Test of Biopesticides against Foc Race 1
2.9. Population of Microorganisms in the Soil
2.10. Data Analysis
3. Results
3.1. Biocontrol of FWB under Greenhouse
3.1.1. Concentration of the Active Ingredients in Bioproducts
3.1.2. Biocontrol Activity of Biofungicides against FWB
3.1.3. Molecular Detection of the Pathogen in Plant Tissue
3.1.4. Effect of Treatments on Physiological and Plant Growth Variables
Plant Physiology Response
Plant Growth Response
3.1.5. In Vitro Antagonism against Foc Race 1
4. Discussion
5. Conclusions
Supplementary Materials
Author Contributions
Funding
Institutional Review Board Statement
Informed Consent Statement
Data Availability Statement
Acknowledgments
Conflicts of Interest
References
- Voora, V.; Larrea, C.; Bermúdez, S. Global Market Report: Bananas. International Institute for Sustainable Development. 2020. Available online: https://www.iisd.org/publications/report/global-market-report-bananas (accessed on 7 September 2023).
- Altendorf, S. Banana Fusarium Wilt Tropical Race 4: A mounting threat to global banana markets? In Food Outlook—Biannual Report on Global Food Markets; FAO: Rome, Italy, 2019; Available online: https://www.fao.org/3/ca6911en/CA6911EN_TR4EN.pdf (accessed on 20 December 2023).
- Altendorf, S. Bananas and Major Tropical Fruits in Latin America and the Caribbean: The Significance of the Region to World Supply. In Food Outlook—Biannual Report on Global Food Markets; FAO: Rome, Italy, 2019. [Google Scholar]
- Dita, M.A.; Garming, H.; Van den Bergh, I.; Staver, C.; Lescot, T. Banana in Latin America and the Caribbean: Current state, challenges and perspectives. Acta Hortic. 2013, 986, 365–380. [Google Scholar] [CrossRef]
- López-Zapata, S.P.; Castaño-Zapata, J. Manejo integrado del mal de Panamá Fusarium oxysporum Schlechtend.: Fr. sp. cubense (E.F. SM.) W.C. Snyder & H.N. Hansen: Una revisión. Rev. U.D.C.A. Actual. Divulg. Científica 2019, 22, e1240. [Google Scholar] [CrossRef]
- Kema, G.H.; Drenth, A.; Dita, M.; Jansen, K.; Vellema, S.; Stoorvogel, J.J. Fusarium wilt of banana, a recurring threat to global banana production. Front. Plant Sci. 2021, 11, 628888. [Google Scholar] [CrossRef] [PubMed]
- Dita, M.; Barquero, M.; Heck, D.; Mizubuti, E.S.; Staver, C.P. Fusarium wilt of banana: Current knowledge on epidemiology and research needs toward sustainable disease management. Front. Plant Sci. 2018, 9, 1468. [Google Scholar] [CrossRef] [PubMed]
- Pegg, K.G.; Coetes, L.M.; O’Neill, W.T.; Turner, D.W. The epidemiology of Fusarium Wilt of Banana. Front. Plant Sci. 2019, 10, 1395. [Google Scholar] [CrossRef] [PubMed]
- Fones, H.N.; Bebber, D.P.; Chaloner, T.M.; Kay, W.T.; Steinberg, G.; Gurr, S.J. Threats to global food security from emerging fungal and oomycete crop pathogens. Nat. Food. 2020, 1, 332–342. [Google Scholar] [CrossRef]
- García-Bastidas, F.A.; Quintero-Vargas, J.C.; Ayala-Vasquez, M.; Schermer, T.; Seidl, M.F.; Santos-Paiva, M.; Noguera, A.M.; Aguilera-Galvez, C.; Wittenberg, A.; Hofstede, R.; et al. First report of Fusarium wilt Tropical Race 4 in Cavendish bananas caused by Fusarium odoratissimum in Colombia. Plant Dis. 2019, 104, 994. [Google Scholar] [CrossRef]
- Rodríguez-Yzquierdo, G.; Olivares, B.O.; Silva-Escobar, O.; González-Ulloa, A.; Soto-Suarez, M.; Betancourt-Vásquez, M. Mapping of the susceptibility of colombian Musaceae lands to a deadly disease: Fusarium oxysporum f. sp. cubense Tropical Race 4. Horticulturae 2023, 9, 757. [Google Scholar] [CrossRef]
- Yadav, K.; Damodaran, T.; Dutt, K.; Singh, A.; Muthukumar, M.; Rajan, S.; Gopal, R.; Sharma, P.C. Effective biocontrol of banana fusarium wilt tropical race 4 by a bacillus rhizobacteria strain with antagonistic secondary metabolites. Rhizosphere 2021, 18, 100341. [Google Scholar] [CrossRef]
- Carmona, S.L.; Villarreal, A.; Burbano-David, D.; Gómez, M.; Torres-Rojas, E.; Soto-Suárez, M. Protection of tomato plants against Fusarium oxysporum f. sp. lycopersici induced by chitosan. Rev. Colomb. Cienc. Hortic. 2020, 15, e12822. [Google Scholar] [CrossRef]
- Zakaria, M.A.T.; Sakimin, S.Z.; Ismail, M.R.; Ahmad, K.; Kasim, S.; Baghdadi, A. Biostimulant Activity of Silicate Compounds and Antagonistic Bacteria on Physiological Growth Enhancement and Resistance of Banana to Fusarium Wilt Disease. Plants 2023, 12, 1124. [Google Scholar] [CrossRef]
- Dita, M.; Teixeira, L.A.J.; O’Neill, W.; Pattison, A.B.; Weinert, M.P.; Li, C.Y.; Zheng, S.J.; Staver, C.; Thangavelu, R.; Viljoen, A. Current state of Fusarium wilt of banana in the subtropics. Acta Hortic. 2020, 1272, 45–56. [Google Scholar] [CrossRef]
- Izquierdo-García, L.F.; Carmona, S.L.; Zuluaga, P.; Rodríguez, G.; Dita, M.; Betancourt, M.; Soto-Suárez, M. Efficacy of disinfectants against Fusarium oxysporum f. sp. cubense Tropical Race 4 Isolated from La Guajira, Colombia. J. Fungi 2021, 7, 297. [Google Scholar] [CrossRef] [PubMed]
- Dale, J.; James, A.; Paul, J.Y.; Khanna, H.; Smith, M.; Peraza-Echeverria, S.; Garcia-Bastidas, F.; Kema, G.; Waterhouse, P.; Mengersen, K.; et al. Transgenic Cavendish bananas with resistance to Fusarium wilt tropical race 4. Nat. Commun. 2017, 8, 1496. [Google Scholar] [CrossRef] [PubMed]
- Mintoff, S.J.L.; Nguyen, T.V.; Kelly, C.; Cullen, S.; Hearnden, M.; Williams, R.; Daniells, J.W.; Tran-Nguyen, L.T.T. Banana cultivar field screening for resistance to Fusarium oxysporum f. sp. cubense Tropical Race 4 in the Northern territory. J. Fungi. 2021, 7, 627. [Google Scholar] [CrossRef] [PubMed]
- Shen, Z.; Xue, C.; Penton, C.R.; Thomashow, L.S.; Zhang, N.; Wang, B.; Ruan, Y.; Li, R.; Shen, Q. Suppression of banana Panama disease induced by soil microbiome reconstruction through an integrated agricultural strategy. Soil Biol. Biochem. 2019, 128, 164–174. [Google Scholar] [CrossRef]
- Jamil, F.N.; Hashim, A.M.; Yusof, M.T.; Saidi, N.B. Analysis of soil bacterial communities and physicochemical properties associated with Fusarium wilt disease of banana in Malaysia. Sci. Rep. 2022, 12, 999. [Google Scholar] [CrossRef] [PubMed]
- Dror, B.; Amutuhaire, H.; Frenkel, O.; Jurkevitch, E.; Cytryn, E. Identification of bacterial populations and functional mechanisms potentially involved in biochar-facilitated antagonism of the soilborne pathogen Fusarium oxysporum. Phytobiomes J. 2022, 6, 139–150. [Google Scholar] [CrossRef]
- Gazolla, C.; Britto, B.; Freitas, J.; Beneduzi, A.; Eichelberger, G.; Kayser, L. Soil-plant-microbiota interaction to enhance plant growth. Rev. Bras. Cienc. Solo 2022, 46, e0210098. [Google Scholar] [CrossRef]
- Zhu, Z.; Wu, G.; Deng, R.; Hu, X.; Tan, H.; Chen, Y.; Tian, Z.; Li, J. Spatiotemporal biocontrol and rhizosphere microbiome analysis of Fusarium wilt of banana. Commun. Biol. 2023, 6, 27. [Google Scholar] [CrossRef]
- Haddad, F.; Rocha, L.S.; Soares, A.C.F.; Martins, I.P.S.; Teixeira, L.A.J.; Staver, C.; Dita, M. Management of Fusarium wilt of bananas in Minas Gerais, Brazil. Acta Hortic. 2018, 1196, 137–145. [Google Scholar] [CrossRef]
- Nowembabazi, A.; Tautaya, G.; Tinzaara, W.; Karamura, E. Effect of integrated potassium nutrition on Fusarium wilt tolerance in apple banana. Afr. J. Plant Sci. 2021, 15, 257–265. [Google Scholar] [CrossRef]
- Yang, J.; Ren, X.; Liu, M.; Fan, P.; Ruan, Y.; Zhao, Y.; Wang, B.; Li, R. Suppressing soil-borne Fusarium pathogens of bananas by planting different cultivars of pineapples, with comparisons of the resulting bacterial and fungal communities. Appl. Soil Ecol. 2022, 169, 104211. [Google Scholar] [CrossRef]
- Teixeira, L.; Nomura, E.; Damatto, E.; Vieira, H.; Staver, C.; Dita, M. Effectiveness of soil management practices on Fusarium wilt of banana in the Ribeira Valley, Brazil. Trop. Plant Pathol. 2022, 47, 411–420. [Google Scholar] [CrossRef]
- Fira, D.; Dimkić, I.; Berić, T.; Lozo, J.; Stanković, S. Biological control of plant pathogens by Bacillus species. J. Biotechnol. 2018, 285, 44–55. [Google Scholar] [CrossRef] [PubMed]
- Pattison, A.; Limbaga, C.; Gervacio, T.; Notarte, A.; Juruena, M.; Dennis, P.; Lindsay, S. Molina. Integrated Management of Fusarium wilt of Banana in the Philippines and Australia. Final Report. Australian Centre for International Agricultural Research—ACIAR. 2020; 91p. Available online: https://www.aciar.gov.au/publication/integrated-management-fusarium-wilt-bananas-philippines-and-australia-final-report (accessed on 20 November 2023).
- Bubici, G.; Kaushal, M.; Prigigallo, M.I.; Gómez-Lama, C.; Mercado-Blanco, J. Biological control agents against Fusarium wilt of banana. Front. Microbiol. 2019, 10, 616. [Google Scholar] [CrossRef] [PubMed]
- Thambugala, K.M.; Daranagama, D.A.; Phillips, A.J.L.; Kannangara, S.D.; Promputtha, I. Fungi vs. Fungi in Biocontrol: An Overview of Fungal Antagonists Applied Against Fungal Plant Pathogens. Front. Cell. Infect. Microbiol. 2020, 10, 604923. [Google Scholar] [CrossRef] [PubMed]
- Wang, Q.; Zhou, L.; Jin, H.; Cong, B.; Yang, H.; Wang, S. Investigating the responses of microbial communities to banana Fusarium wilt in suppressive and conductive soils based on soil particle size differentiation. Agronomy 2022, 12, 229. [Google Scholar] [CrossRef]
- Sharma, A.; Gupta, B.; Verma, S.; Pal, J.; Akanksha, M.; Chauhan, P. Unveiling the biocontrol potential of Trichoderma. Eur. J. Plant Pathol. 2023, 167, 569–591. [Google Scholar] [CrossRef]
- Tyśkiewicz, R.; Nowak, A.; Ozimek, E.; Jaroszuk-Ściseł, J. Trichoderma: The current status of its application in agriculture for the biocontrol of fungal phytopathogens and stimulation of plant growth. Int. J. Mol. Sci. 2022, 23, 2329. [Google Scholar] [CrossRef]
- Pérez-García, A.; Romero, D.; de Vicente, A. Plant protection and growth stimulation by microorganisms: Biotechnological applications of Bacilli in agriculture. Curr. Opin. Biotech. 2011, 22, 187–193. [Google Scholar] [CrossRef] [PubMed]
- Monaci, L.; Quintieri, L.; Caputo, L.; Visconti, A.; Baruzzi, F. Rapid profiling of antimicrobial compounds characterizing B. subtilis TR50 cell-free filtrate by high performance liquid chromatography coupled to high-resolution Orbitrap™ mass spectrometry. Rapid Commun. Mass Spectrom. 2016, 30, 45–53. [Google Scholar] [CrossRef] [PubMed]
- Fan, B.; Blom, J.; Klenk, H.-P.; Borriss, R. Bacillus amyloliquefaciens, Bacillus velezensis, and Bacillus siamensis Form an “Operational Group B. amyloliquefaciens” within the B. subtilis Species Complex. Front. Microbiol. 2017, 8, 22. [Google Scholar] [CrossRef] [PubMed]
- Bais, H.P.; Fall, R.; Vivanco, J.M. Biocontrol of Bacillus subtilis against infection of Arabidopsis roots by Pseudomonas syringae is facilitated by biofilm formation and surfactin production. J. Plant Physiol. 2004, 134, 307–319. [Google Scholar] [CrossRef] [PubMed]
- Chen, X.H.; Scholz, R.; Borriss, M.; Junge, H.; Mögel, G.; Kunz, S.; Borriss, R. Difficidin and bacilysin produced by plant-associated Bacillus amyloliquefaciens are efficient in controlling fire blight disease. J. Biotechnol. 2009, 140, 38–44. [Google Scholar] [CrossRef] [PubMed]
- Cawoy, H.; Debois, D.; Franzil, L.; De Pauw, E.; Thonart, P.; Ongena, M. Lipopeptides as main ingredients for inhibition of fungal phytopathogens by Bacillus subtilis/amyloliquefaciens. Microb. Biotechnol. 2014, 8, 281–295. [Google Scholar] [CrossRef]
- Malfanova, N.; Franzil, L.; Lugtenberg, B.; Chebotar, V.; Ongena, M. Cyclic lipopeptide profile of the plant-beneficial endophytic bacterium Bacillus subtilis HC8. Arch. Microbiol. 2012, 194, 893–899. [Google Scholar] [CrossRef] [PubMed]
- Moreno-Velandia, C.A.; Ongena, M.; Cotes, A.M. Effects of Fengycins and Iturins on Fusarium oxysporum f. sp. physali and root colonization by Bacillus velezensis Bs006 protect golden berry against vascular wilt. Phytopathology 2021, 111, 2227–2237. [Google Scholar] [CrossRef]
- Cawoy, H.; Mariutto, M.; Henry, G.; Fisher, C.; Vasilyeva, N.; Thonart, P.; Domes, J.; Ongena, M. Plant defense stimulation by natural isolates of Bacillus depends on efficient surfactin production. Mol. Plant Microb. Interact. 2014, 27, 87–100. [Google Scholar] [CrossRef]
- Pertot, I.; Puopolo, G.; Hosni, T.; Pedrotti, L.; Jourdan, E.; Ongena, M. Limited impact of abiotic stress on surfactin production in planta and on disease resistance induced by Bacillus amyloliquefaciens S499 in tomato and bean. FEMS Microbiol. Ecol. 2013, 86, 505–519. [Google Scholar] [CrossRef]
- Ongena, M.; Jourdan, E.; Adam, A.; Paquot, M.; Brans, A.; Joris, B.; Arpigny, J.-L.; Thonart, P. Surfactin and fengycin lipopeptides of Bacillus subtilis as elicitors of induced systemic resistance in plants. Environ. Microbiol. 2007, 9, 1084–1090. [Google Scholar] [CrossRef]
- Chen, K.; Tian, Z.; He, H.; Long, C.; Jiang, F. Bacillus species as potential biocontrol agents against citrus diseases. Biol. Control 2020, 151, 104419. [Google Scholar] [CrossRef]
- Khan, N.; Maymon, M.; Hirsch, A.M. Combating Fusarium Infection Using Bacillus-Based Antimicrobials. Microorganisms 2017, 5, 75. [Google Scholar] [CrossRef]
- Miljaković, D.; Marinković, J.; Balešević-Tubić, S. The Significance of Bacillus spp. in disease suppression and growth promotion of field and vegetable crops. Microorganisms 2020, 8, 1037. [Google Scholar] [CrossRef]
- Ntushelo, K.; Ledwaba, L.K.; Rauwane, M.E.; Adebo, O.A.; Njobeh, P.B. The mode of action of Bacillus species against Fusarium graminearum, tools for investigation, and future prospects. Toxins 2019, 11, 606. [Google Scholar] [CrossRef] [PubMed]
- Saxena, A.K.; Kumar, M.; Chakdar, C.; Anuroopa, N.; Bagyaraj, D.J. Bacillus species in soil as a natural resource for plant health and nutrition. J. Appl. Microbiol. 2019, 6, 1583–1594. [Google Scholar] [CrossRef]
- Shafi, J.; Tian, H.; Ji, M. Bacillus species as versatile weapons for plant pathogens: A review. Biotechnol. Biotec. Equip. 2017, 31, 446–459. [Google Scholar] [CrossRef]
- Akila, R.; Rajendran, L.; Harish, S.; Saveetha, K.; Raguchander, T.; Samiyappan, R. Combined application of botanical formulations and biocontrol agents for the management of Fusarium oxysporum f. sp. cubense (Foc) causing Fusarium wilt in banana. Biol. Control 2011, 57, 175–183. [Google Scholar] [CrossRef]
- Thangavelu, R.; Gopi, M. Combined application of native Trichoderma isolates possessing multiple functions for the control of Fusarium wilt disease in banana cv. Grand Naine. Biocontrol Sci. Technol. 2015, 25, 1147–1164. [Google Scholar] [CrossRef]
- Wong, N.B.; Saidi, G.; Vadamalai, C.Y.; Zulperi, D. Effect of bioformulations on the biocontrol efficacy, microbial viability and storage stability of a consortium of biocontrol agents against Fusarium wilt of banana. J. Appl. Microbiol. 2019, 127, 544–555. [Google Scholar] [CrossRef]
- Li, Y.; Jiang, S.; Jiang, J.; Gao, C.; Qi, X.; Zhang, L.; Sun, S.; Dai, Y.; Fan, X. Synchronized efficacy and mechanism of alkaline fertilizer and biocontrol fungi for Fusarium oxysporum f. sp. cubense Tropical Race 4. J. Fungi 2022, 8, 261. [Google Scholar] [CrossRef] [PubMed]
- ICA. 2023. Bioinsumos Registrados a 1 de Diciembre de 2023. Available online: https://www.ica.gov.co/areas/agricola/servicios/fertilizantes-y-bio-insumos-agricolas/listado-de-bioinsumos/2023/6-bd_productos-bioinsumos_19-de-abril-de-2023-1.aspx (accessed on 29 December 2023).
- Dita, M.; Teixeira, L.; Li, C.; Zheng, S.; O’Neill, W.; Daniels, J.; Pérez-Vicente, L.; Carreel, F.; Roussel, V.; Carlier, J.; et al. Practical Guidelines for Early Screening and Field Evaluation of Banana against Fusarium wilt, Pseudocercospora Leaf Spots and Drought; Bioversity International: Montpellier, France, 2021; 83p, Available online: https://hdl.handle.net/10568/111159 (accessed on 20 January 2023).
- Mateus-Cagua, D.; Rodríguez-Yzquierdo, G. Effect of biostimulants on dry matter accumulation and gas exchange in plantain plants (Musa AAB). Rev. Colomb. Cienc. Hortícolas 2019, 13, 151–160. [Google Scholar] [CrossRef]
- Carvalhais, L.C.; Henderson, J.; Rincon-Florez, V.A.; O’Dwyer, C.; Czislowski, E.; Aitken, E.A.; Drenth, A. Molecular diagnostics of banana Fusarium Wilt targeting secreted-in-xylem genes. Front. Plant Sci. 2019, 10, 547. [Google Scholar] [CrossRef] [PubMed]
- Daire, X.; Clair, D.; Reinert, W.; Boudon-Padieu, E. Detection and differentiation of grapevine yellows phytoplasmas belonging to the elm yellows group and to the stolbur subgroup by PCR amplification of non-ribosomal DNA. Eur. J. Plant Pathol. 1997, 103, 507–514. [Google Scholar] [CrossRef]
- Mansoor, S.; Qazi, J.; Amin, I.; Khatri, A.; Khan, I.A.; Raza, S.; Zafar, Y.; Briddon, R.W. A PCR-based method, with internal control, for the detection of banana bunchy top virus in banana. Mol. Biotechnol. 2005, 30, 167–169. [Google Scholar] [CrossRef] [PubMed]
- Nayak, D.; Mishra, M.K.; Pradhan, B.; Sharma, K.K. Evaluation of some bio-control agents in in vitro control of Fusarium oxysporum f. sp. cubense, an incitant of banana panama wilt. J. Pharmacogn. Phytochem. 2020, 9, 751–753. Available online: https://www.phytojournal.com/archives/2020.v9.i3.11365/evaluation-of-some-bio-control-agents-in-in-vitro-control-of-fusarium-oxysporum-f-sp-cubense-an-incitant-of-banana-panama-wilt (accessed on 20 December 2023).
- Segarra, G.; Casanova, E.; Avilés, M.; Trillas, I. Trichoderma asperellum strain T34 controls Fusarium wilt disease in tomato plants in soilless culture through competition for iron. Microb. Ecol. 2010, 59, 141–149. [Google Scholar] [CrossRef] [PubMed]
- Dong, X.; Wang, M.; Ling, N.; Shen, Q.; Guo, S. Potential role of photosynthesis-related factors in banana metabolism and defense against Fusarium oxysporum f. sp. cubense. Environ. Exp. Bot. 2016, 129, 4–12. [Google Scholar] [CrossRef]
- Lawson, T.; Oxborough, K.; Morison, J.I.L.; Baker, N.R. Responses of photosynthetic electron transport in stomatal guard cells and mesophyll cells in intact leaves to light, CO2 and humidity. Plant Physiol. 2002, 128, 52–62. [Google Scholar] [CrossRef]
- Tambussi, E.A.; Casadesus, J.; Munné-Bosch, S.; Araus, J.L. Photoprotection in water stressed plants of durum wheat (Triticum turgidum var. durum): Changes in chlorophyll fluorescence, spectral signature and photosynthetic pigments. Funct. Plant Biol. 2002, 29, 35–44. [Google Scholar] [CrossRef]
- Moustaka, J.; Moustakas, M. Early-stage detection of biotic and abiotic stress on plants by chlorophyll fluorescence imaging analysis. Biosensors 2023, 13, 796. [Google Scholar] [CrossRef] [PubMed]
- Pérez-Bueno, M.L.; Pineda, M.; Barón, M. Phenotyping plant responses to biotic stress by chlorophyll fluorescence imaging. Front. Plant Sci. 2019, 10, 1135. [Google Scholar] [CrossRef]
- Goltsev, V.N.; Kalaji, H.M.; Paunov, M.; Bąba, W.; Horaczek, T.; Mojski, J.; Kociel, H.; Allakhverdiev, S.I. Variable chlorophyll fluorescence and its use for assessing physiological condition of plant photosynthetic apparatus. Russ. J. Plant Physl. 2016, 63, 869–893. [Google Scholar] [CrossRef]
- Cheng, C.; Li, D.; Qi, Q.; Sun, X.; Anue, M.R.; David, B.M.; Zhang, Y.; Hao, X.; Zhang, Z.; Lai, Z. The root endophytic fungus Serendipita indica improves resistance of banana to Fusarium oxysporum f. sp. cubense tropical race 4. Eur. J. Plant Pathol. 2020, 156, 87–100. [Google Scholar] [CrossRef]
- Ibrahimova, U.; Zivcak, M.; Gasparovic, K.; Rastogi, A.; Allakhverdiev, S.I.; Yang, X.; Brestic, M. Electron and proton transport in wheat exposed to salt stress: Is the increase of the thylakoid membrane proton conductivity responsible for decreasing the photosynthetic activity in sensitive genotypes? Photosynth. Res. 2021, 150, 195–211. [Google Scholar] [CrossRef]
- Noctor, G.; Veljovic-Jovanovic, S.; Driscoll, S.; Novitskaya, L.; Foyer, C. Drought and oxidative load in the leaves of C3 plants: A predominant role for photorespiration. Ann. Bot. 2002, 89, 841–850. [Google Scholar] [CrossRef] [PubMed]
- Basso, C.; Rodríguez-Yzquierdo, G.; Rivero, G.; León, R.; Barrios, M.; Díaz, G. Respuesta del cultivo de maracuyá (Passiflora edulis Sims) a condiciones de estrés por inundación. Bioagro 2019, 31, 185–192. Available online: https://dialnet.unirioja.es/servlet/articulo?codigo=7146779 (accessed on 15 December 2023).
- Bueno, A.; Castro, G.; Rêgo, M.; Batista, T.; Filippi, M.; da Silva, G. Trichoderma reduces scald and protects the photosynthetic apparatus in rice plants. Biocontrol Sci. Technol. 2017, 27, 449–460. [Google Scholar] [CrossRef]
- Wong, C.; Zulperi, D.; Saidi, N.B.; Vadamalai, G.A. Consortium of Pseudomonas aeruginosa and Trichoderma harzianum for improving growth and induced biochemical changes in Fusarium wilt infected bananas. Trop. Life Sci. Res. 2021, 32, 23–45. [Google Scholar] [CrossRef]
- Sajeena, A.; Nair, D.S.; Sreepavan, K. Non-pathogenic Fusarium oxysporum as a biocontrol agent. Indian Phytopathol. 2020, 73, 177–183. [Google Scholar] [CrossRef]
- Castillo, A.G.; Puig, C.G.; Cumagun, C.J.R. Non-synergistic effect of Trichoderma harzianum and Glomus spp. in reducing infection of Fusarium wilt in banana. Pathogens 2019, 8, 43. [Google Scholar] [CrossRef]
- Doni, F.; Isahak, A.; Zain, C.R.C.M.; Ariffin, S.M.; Mohamad, W.N.W.; Yusoff, W.M.W. Formulation of Trichoderma sp. SL2 inoculants using different carriers for soil treatment in rice seedling growth. SpringerPlus 2014, 3, 532. [Google Scholar] [CrossRef] [PubMed]
- Penyalver, R.; Vicedo, B.; López, M.M. Use of the genetically engineered Agrobacterium strain K1026 for biological control of crown gall. Eur. J. Plant Pathol. 2000, 106, 801–810. [Google Scholar] [CrossRef]
- Vicedo, B.; Peñalver, R.; Asins, M.J.; López, M.M. Biological control of Agrobacterium tumefaciens, colonization, and pAgK84 transfer with Agrobacterium radiobacter K84 and the Tra mutant strain K1026. Appl. Environ. Microbiol. 1993, 59, 309–315. [Google Scholar] [CrossRef] [PubMed]
- Peñalver, R.; Vicedo, B.; Salcedo, C.I.; López, M.M. Agrobacterium radiobacter strains K84, K1026 and K84 Agr- produce an antibiotic-like substance, active in vitro against A. tumefaciens and phytopathogenic Erwinia and Pseudomonas spp. Biocontrol Sci. Technol. 1994, 4, 259–267. [Google Scholar] [CrossRef]
- Marshall, K.C.; Alexander, M. Competition between soil bacteria and Fusarium. Plant Soil. 1960, 12, 143–153. [Google Scholar] [CrossRef]
- Köhl, J.; Kolnaar, R.; Ravensberg, W.J. Mode Action of Microbial Biological Control Agents Against Plant Diseases: Relevance Beyond Efficacy. Front. Plant Sci. 2019, 10, 845. [Google Scholar] [CrossRef]
- El-Wakeil, N.; Saleh, M.; Abu-hashim, M. (Eds.) Cottage Industry of Biocontrol Agents and Their Applications. Practical Aspects to Deal Biologically with Pests and Stresses Facing Strategic Crops; Springer: Cham, Switzerland, 2020; 466p. [Google Scholar] [CrossRef]
- Lin, P.; Zhang, M.Y.; Wang, M.Y.; Li, Y.Q.; Liu, J.F.; Chen, Y.L. Inoculation with arbuscular mycorrhizal fungi modulates defense-related genes expression in banana seedlings susceptible to wilt disease. Plant Signal Behav. 2021, 16, e1884782. [Google Scholar] [CrossRef]

| Treatment | Active Ingredient | Target Pathosystem | Formulation | Concentration (CFU g−1 or mL−1) |
|---|---|---|---|---|
| T1 | T. harzianum | F. oxysporum—Carnation | WP | 1.0 × 108 |
| T2 | T. harzianum | F. oxysporum—Carnation | WP | 2.0 × 108 |
| T3 | T. koningiopsis | F. oxysporum—Tomato | WDG | 1.0 × 109 |
| T4 | T. harzianum, T. koningii, T. viride | Various soil-borne phytopathogens | WP | 1.0 × 108 |
| T5 | B. subtilis | F. oxysporum—tomato | SC | 5.0 × 109 |
| T6 | B. subtilis, B. pumilus, B. thuringensis var. kurstaki, B. amyloliquefaciens | F. oxysporum—tomato, cape gooseberry, lulo, tree tomato, chili pepper, pepper, and egg plant | SC | 4.0 × 108 |
| T7 | B. amyloliquefaciens, Agrobacterium radiobacter, B. pumilus | Known performance against F. oxysporum—Carnation at experimental level | SC | 2.5 × 108 |
| T8 | B. amyloliquefaciens | Mycosphaerella fijiensis—banana | SC | 1.0 × 109 |
| T9 | Mixture of Trichoderma harzianum strains (no formulated) | Applied by commercial banana growers | Unformulated conidia | |
| Parameters a | Statistics b | |||||||||||
|---|---|---|---|---|---|---|---|---|---|---|---|---|
| Treatment | K | r | t0 | F | Pr > F | R2 | Growth Rate (%) c | Final INC (%) d | CV e INC | AUDPC-INC f (% x Weeks) | CV g AUDPC | AUDPC Reduction (%) h |
| T1 | 89.3 | 1.28 | 6.6 | 264.38 | <0.0001 | 0.999 | 22.7 | 88.89 | 16.35 | 322.70 | 24.88 | 29.90 (4.3) bc |
| T2 | 73.7 | 1.2 | 7.0 | 90.13 | <0.0001 | 1.000 | 17.3 | 71.11 | 28.51 | 243.65 | 51.32 | 49.72 (7.0) b |
| T3 | 68.2 | 1.4 | 6.1 | 95.88 | <0.0001 | 1.000 | 21.1 | 68.89 | 38.71 | 292.06 | 41.31 | 37.12 (7.0) bc |
| T4 | 88.54 | 1.19 | 6.82 | 127.38 | <0.0001 | 1.000 | 20.8 | 86.67 | 19.99 | 298.89 | 47.42 | 37.38 (7.6) bc |
| T5 | 85.11 | 1.23 | 6.36 | 190.47 | <0.0001 | 0.997 | 24.8 | 84.44 | 25.88 | 337.94 | 35.61 | 28.22 (8.3) c |
| T6 | 93.60 | 1.23 | 6.20 | 300.01 | <0.0001 | 0.999 | 22.2 | 95.56 | 9.23 | 379.37 | 27.95 | 20.77 (6.4) c |
| T7 | 64.48 | 0.77 | 8.22 | 37.53 | <0.0001 | 0.991 | 10.1 | 53.33 | 62.19 | 128.10 | 77.33 | 73.90 (6.5) a |
| T8 | 93.32 | 1.30 | 6.17 | 301.30 | <0.0001 | 1.000 | 23.1 | 91.11 | 15.95 | 394.44 | 21.52 | 19.47 (5.2) c |
| T9 | 89.69 | 1.09 | 5.81 | 216.27 | <0.0001 | 0.999 | 23.5 | 88.89 | 19.84 | 419.05 | 34.05 | 14.57 (5.1) c |
| T10 | 98.74 | 1.30 | 5.83 | 556.26 | <0.0001 | 0.999 | 29.1 | 97.78 | 6.82 | 462.06 | 20.37 | - |
| Treatment | Reduction of AUDPC DII (%) per Replicate * | ||
|---|---|---|---|
| 1st | 2nd | 3rd | |
| T1 | 18.6 ± 36.2 | 8.1 ± 23.3 | 47.3 ± 10.7 |
| T2 | 70.9 ± 18.8 | 28.8 ± 22.3 | 46.3 ± 5.8 |
| T3 | 30.7 ± 34.2 | 2.1 ± 11.3 | 69.4 ± 12.6 |
| T4 | 47.8 ± 31.4 | −5.4 ± 28.5 | 50.7 ± 17.6 |
| T5 | 6.5 ± 68.1 | 21.2 ± 17.0 | 59.2 ± 11.7 |
| T6 | −0.9 ± 14.1 | 19.6 ± 41.5 | −5.2 ± 77.9 |
| T7 | 90.9 ± 14.6 | 81.4 ± 14.9 | 60.0 ± 10.3 |
| T8 | −46.1 ± 54.5 | 15.9 ± 14.2 | 41.1 ± 25.4 |
| T9 | 26.9 ± 25.0 | −5.2 ± 24.5 | 1.8 ± 20.1 |
| Net Assimilation Rate (A) | Transpiration Rate (E) | PSII Photochemical Yield | Quantum Efficiency of PSII | |||||||||||||||||||||
|---|---|---|---|---|---|---|---|---|---|---|---|---|---|---|---|---|---|---|---|---|---|---|---|---|
| (μmol m−² s−¹) | (mol m−² s−¹) | Y(II) | (Fv/Fm) | |||||||||||||||||||||
| 49 Days after Transplant | ||||||||||||||||||||||||
| R1 | R2 | R3 | R1 | R2 | R3 | R1 | R2 | R3 | R1 | R2 | R3 | |||||||||||||
| T1 | 9.74 | abc | 5.54 | abc | 4.95 | abcde | 0.004 | bcd | 0.000 | a | 0.002 | a | 0.83 | a | 0.13 | ab | 0.08 | a | 0.56 | a | 0.80 | a | 0.55 | a |
| T2 | 13.94 | ab | 8.30 | ab | 1.00 | e | 0.005 | abc | 0.001 | a | 0.001 | a | 0.14 | a | 0.11 | ab | 0.06 | ab | 0.83 | a | 0.77 | a | 0.54 | a |
| T3 | 8.39 | abc | 0.00 | c | 3.12 | bcde | 0.003 | bcd | 0.000 | a | 0.001 | a | 0.10 | a | 0.00 | c | 0.08 | a | 0.81 | a | 0.00 | b | 0.55 | a |
| T4 | 10.42 | abc | 5.58 | abc | 2.75 | cde | 0.004 | bcd | 0.000 | a | 0.001 | a | 0.14 | a | 0.07 | bc | 0.13 | a | 0.84 | a | 0.53 | a | 0.83 | a |
| T5 | 11.03 | abc | 4.08 | abc | 9.96 | abc | 0.005 | abcd | 0.001 | a | 0.003 | a | 0.13 | a | 0.18 | a | 0.13 | a | 0.83 | a | 0.79 | a | 0.82 | a |
| T6 | 6.69 | bc | 4.67 | abc | 0.00 | e | 0.002 | cd | 0.000 | a | 0.000 | a | 0.13 | a | 0.15 | ab | 0.00 | b | 0.75 | a | 0.81 | a | 0.00 | b |
| T7 | 13.43 | abc | 10.47 | a | 10.45 | abc | 0.006 | abc | 0.000 | a | 0.005 | a | 0.14 | a | 0.15 | ab | 0.12 | a | 0.83 | a | 0.81 | a | 0.80 | a |
| T8 | 4.89 | c | 4.96 | abc | 8.71 | abcd | 0.001 | d | 0.000 | a | 0.004 | a | 0.08 | a | 0.12 | ab | 0.12 | a | 0.55 | a | 0.80 | a | 0.82 | a |
| T9 | 15.63 | a | 5.51 | abc | 1.51 | de | 0.007 | ab | 0.000 | a | 0.001 | a | 0.15 | a | 0.11 | ab | 0.08 | a | 0.83 | a | 0.55 | a | 0.51 | a |
| T10 | 5.72 | bc | 2.01 | bc | 10.69 | ab | 0.001 | d | 0.000 | a | 0.004 | a | 0.09 | a | 0.07 | bc | 0.12 | a | 0.78 | a | 0.52 | a | 0.82 | a |
| T12 | 16.38 | a | 8.29 | ab | 11.05 | a | 0.008 | a | 0.000 | a | 0.005 | a | 0.14 | a | 0.15 | ab | 0.13 | a | 0.84 | a | 0.84 | a | 0.82 | a |
| 70 days after transplant | ||||||||||||||||||||||||
| R1 | R2 | R3 | R1 | R2 | R3 | R1 | R2 | R3 | R1 | R2 | R3 | |||||||||||||
| T1 | 4.43 | a | 0.00 | b | 0.00 | c | 0.001 | a | 0.000 | b | 0.001 | a | 0.05 | ab | 0.00 | c | 0.03 | cd | 0.56 | ab | 0.00 | c | 0.25 | bc |
| T2 | 3.78 | a | 3.59 | ab | 2.32 | ab | 0.000 | a | 0.001 | ab | 0.001 | a | 0.05 | ab | 0.04 | abc | 0.09 | abc | 0.50 | ab | 0.27 | bc | 0.54 | ab |
| T3 | 5.37 | a | 0.00 | b | 0.33 | bc | 0.001 | a | 0.000 | b | 0.001 | a | 0.04 | ab | 0.00 | c | 0.07 | bcd | 0.53 | ab | 0.00 | c | 0.45 | abc |
| T4 | 3.19 | a | 2.63 | ab | 0.83 | bc | 0.000 | a | 0.001 | b | 0.001 | a | 0.04 | ab | 0.07 | abc | 0.11 | abc | 0.48 | ab | 0.38 | abc | 0.77 | a |
| T5 | 4.40 | a | 0.00 | b | 1.43 | bc | 0.001 | a | 0.000 | b | 0.001 | a | 0.04 | ab | 0.00 | c | 0.12 | ab | 0.51 | ab | 0.00 | c | 0.78 | a |
| T6 | 0.15 | a | 0.32 | b | 0.00 | c | 0.000 | a | 0.000 | b | 0.000 | a | 0.01 | ab | 0.02 | bc | 0.00 | d | 0.27 | ab | 0.24 | bc | 0.00 | c |
| T7 | 0.72 | a | 7.56 | a | 0.69 | bc | 0.000 | a | 0.003 | a | 0.002 | a | 0.07 | a | 0.11 | a | 0.08 | abcd | 0.57 | ab | 0.79 | a | 0.53 | ab |
| T8 | 0.00 | a | 3.89 | ab | 0.61 | bc | 0.000 | a | 0.002 | ab | 0.001 | a | 0.00 | b | 0.08 | abc | 0.14 | ab | 0.00 | b | 0.35 | abc | 0.80 | a |
| T9 | 6.07 | a | 3.05 | ab | 2.22 | abc | 0.001 | a | 0.001 | ab | 0.001 | a | 0.04 | ab | 0.06 | abc | 0.00 | d | 0.56 | ab | 0.51 | ab | 0.00 | c |
| T10 | 0.00 | a | 0.00 | b | 0.50 | bc | 0.000 | a | 0.000 | b | 0.001 | a | 0.00 | b | 0.00 | c | 0.07 | bcd | 0.00 | b | 0.00 | c | 0.51 | abc |
| T12 | 4.06 | a | 4.58 | ab | 3.95 | a | 0.000 | a | 0.001 | ab | 0.001 | a | 0.07 | a | 0.11 | ab | 0.16 | a | 0.85 | a | 0.81 | a | 0.80 | a |
Disclaimer/Publisher’s Note: The statements, opinions and data contained in all publications are solely those of the individual author(s) and contributor(s) and not of MDPI and/or the editor(s). MDPI and/or the editor(s) disclaim responsibility for any injury to people or property resulting from any ideas, methods, instructions or products referred to in the content. |
© 2024 by the authors. Licensee MDPI, Basel, Switzerland. This article is an open access article distributed under the terms and conditions of the Creative Commons Attribution (CC BY) license (https://creativecommons.org/licenses/by/4.0/).
Share and Cite
Izquierdo-García, L.F.; Carmona-Gutiérrez, S.L.; Moreno-Velandia, C.A.; Villarreal-Navarrete, A.d.P.; Burbano-David, D.M.; Quiroga-Mateus, R.Y.; Gómez-Marroquín, M.R.; Rodríguez-Yzquierdo, G.A.; Betancourt-Vásquez, M. Microbial-Based Biofungicides Mitigate the Damage Caused by Fusarium oxysporum f. sp. cubense Race 1 and Improve the Physiological Performance in Banana. J. Fungi 2024, 10, 419. https://doi.org/10.3390/jof10060419
Izquierdo-García LF, Carmona-Gutiérrez SL, Moreno-Velandia CA, Villarreal-Navarrete AdP, Burbano-David DM, Quiroga-Mateus RY, Gómez-Marroquín MR, Rodríguez-Yzquierdo GA, Betancourt-Vásquez M. Microbial-Based Biofungicides Mitigate the Damage Caused by Fusarium oxysporum f. sp. cubense Race 1 and Improve the Physiological Performance in Banana. Journal of Fungi. 2024; 10(6):419. https://doi.org/10.3390/jof10060419
Chicago/Turabian StyleIzquierdo-García, Luisa Fernanda, Sandra Lorena Carmona-Gutiérrez, Carlos Andrés Moreno-Velandia, Andrea del Pilar Villarreal-Navarrete, Diana Marcela Burbano-David, Ruth Yesenia Quiroga-Mateus, Magda Rocío Gómez-Marroquín, Gustavo Adolfo Rodríguez-Yzquierdo, and Mónica Betancourt-Vásquez. 2024. "Microbial-Based Biofungicides Mitigate the Damage Caused by Fusarium oxysporum f. sp. cubense Race 1 and Improve the Physiological Performance in Banana" Journal of Fungi 10, no. 6: 419. https://doi.org/10.3390/jof10060419
APA StyleIzquierdo-García, L. F., Carmona-Gutiérrez, S. L., Moreno-Velandia, C. A., Villarreal-Navarrete, A. d. P., Burbano-David, D. M., Quiroga-Mateus, R. Y., Gómez-Marroquín, M. R., Rodríguez-Yzquierdo, G. A., & Betancourt-Vásquez, M. (2024). Microbial-Based Biofungicides Mitigate the Damage Caused by Fusarium oxysporum f. sp. cubense Race 1 and Improve the Physiological Performance in Banana. Journal of Fungi, 10(6), 419. https://doi.org/10.3390/jof10060419

